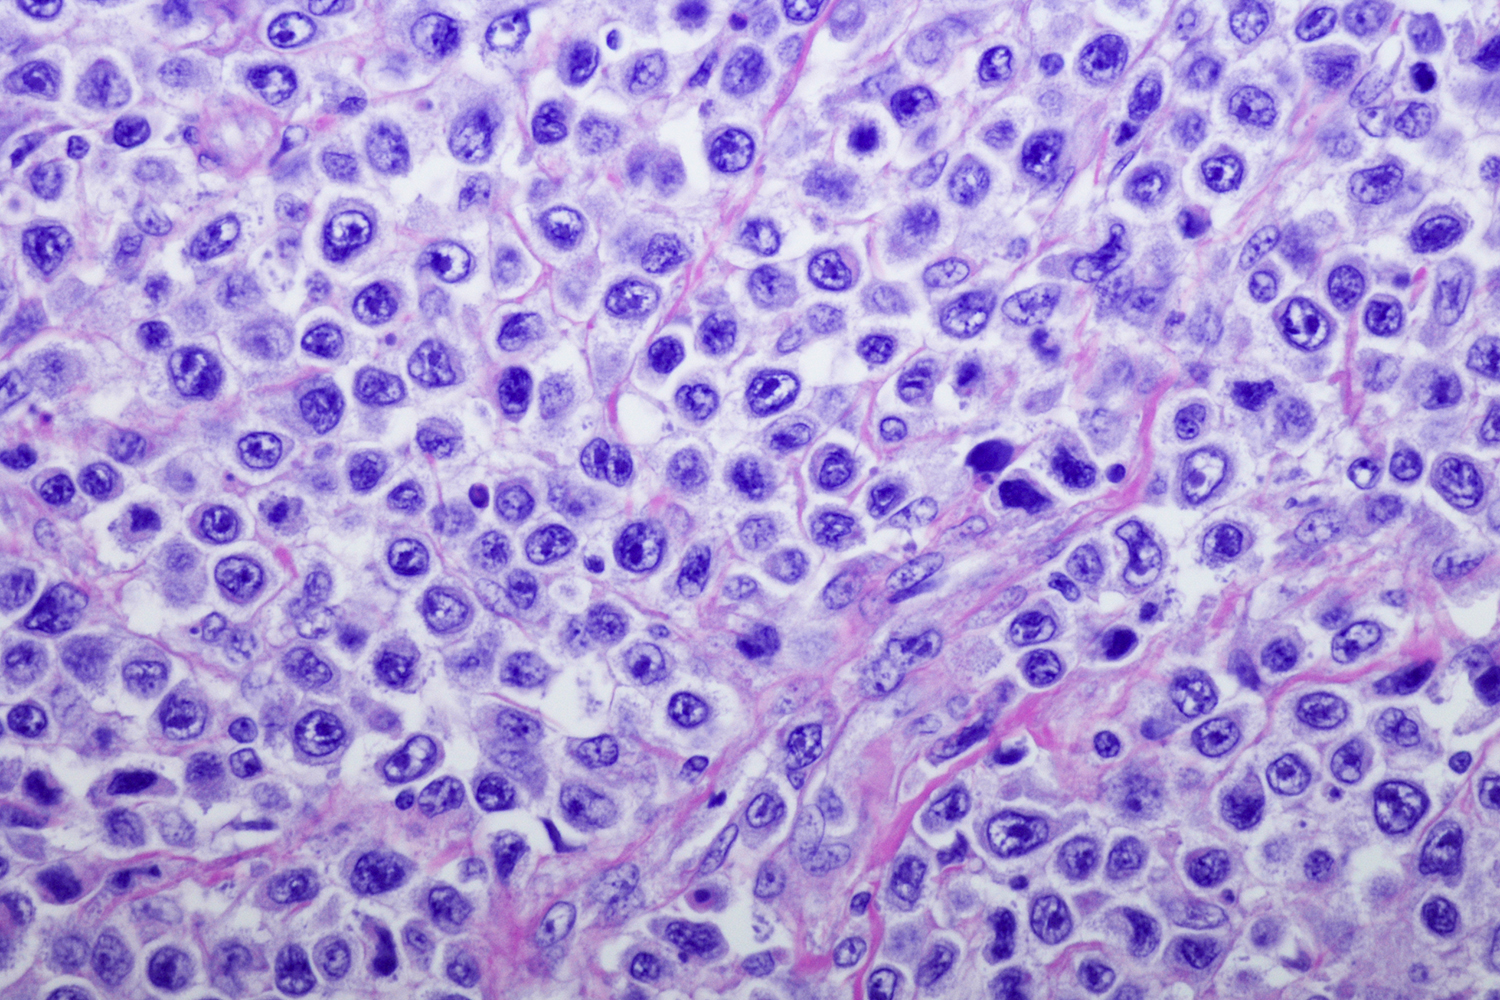
Neetu Gupta Lab

Inflammation & Immunity
Laboratories
Filter by Disease Area:

The Jean-Paul Achkar lab focuses on translational inflammatory bowel disease (IBD) genetics studies and clinical projects.

Jean-Paul Achkar Lab
The Jean-Paul Achkar lab focuses on translational inflammatory bowel disease (IBD) genetics studies and clinical projects.
View Lab
The Mark Aronica lab studies the role of the extracellular matrix in the development and pathogeneis of asthma.

Mark Aronica Lab
The Mark Aronica lab studies the role of the extracellular matrix in the development and pathogeneis of asthma.
View Lab
The Kewal Asosingh lab studies asthma and pulmonary arterial hypertension.

Kewal Asosingh Lab
The Kewal Asosingh lab studies asthma and pulmonary arterial hypertension.
View Lab
The Awoniyi lab studies the microbial mysteries intertwined with primary sclerosing cholangitis and inflammatory bowel diseases.

Olumuyiwa Awoniyi Lab
The Awoniyi lab studies the microbial mysteries intertwined with primary sclerosing cholangitis and inflammatory bowel diseases.
View Lab
The William Baldwin lab studies how antibodies alter lymphocyte responses, informing vascular pathology research.

William Baldwin Lab
The William Baldwin lab studies how antibodies alter lymphocyte responses, informing vascular pathology research.
View Lab
The Leslie Bruggeman lab investigates the molecular and cellular biology of chronic kidney disease.

Leslie Bruggeman Lab
The Leslie Bruggeman lab investigates the molecular and cellular biology of chronic kidney disease.
View Lab
The Suzy Comhair lab focuses on the translational investigation of airway inflammation and oxidative stress in asthma.

Suzy Comhair Lab
The Suzy Comhair lab focuses on the translational investigation of airway inflammation and oxidative stress in asthma.
View Lab
The Gail Cresci lab investigates gut microbiota, targeting alterations in metabolic byproducts and gut dysbiosis.

Gail Cresci Lab
The Gail Cresci lab investigates gut microbiota, targeting alterations in metabolic byproducts and gut dysbiosis.
View Lab
The Dasarathy lab studies how to best manage care for patients who are waiting for or have received liver transplants.

Srinivasan Dasarathy Lab
The Dasarathy lab studies how to best manage care for patients who are waiting for or have received liver transplants.
View Lab
The Raed Dweik lab studies how nitric oxide and other markers in exhaled breath affect lung physiology and disease.

Raed Dweik Lab
The Raed Dweik lab studies how nitric oxide and other markers in exhaled breath affect lung physiology and disease.
View Lab
The Serpil Erzurum lab explores mechanisms that cause and perpetuate lung inflammation and remodeling and lead to lung disease.

Serpil Erzurum Lab
The Serpil Erzurum lab explores mechanisms that cause and perpetuate lung inflammation and remodeling and lead to lung disease.
View Lab
The Robert Fairchild lab studies innate and adaptive immune mechanisms in contact hypersensitivity and organ transplant.

Robert Fairchild Lab
The Robert Fairchild lab studies innate and adaptive immune mechanisms in contact hypersensitivity and organ transplant.
View Lab
The James Finke lab investigates mechanisms by which the tumor microenvironment affects T cell immunity in cancer.

James Finke Lab
The James Finke lab investigates mechanisms by which the tumor microenvironment affects T cell immunity in cancer.
View Lab
The Fiocchi lab studies the pathogenesis of inflammatory bowel diseases such as Crohn's disease and ulcerative colitis.

Claudio Fiocchi Lab
The Fiocchi lab studies the pathogenesis of inflammatory bowel diseases such as Crohn's disease and ulcerative colitis.
View Lab
The Brian Gaudette lab studies how metabolism affects plasma cell differentiation and survival.

Brian Gaudette Lab
The Brian Gaudette lab studies how metabolism affects plasma cell differentiation and survival.
View Lab
The Arnab Ghosh lab studies how cardiopulmonary diseases and inflammatory myopathies may affect hemeprotein maturation.

Arnab Ghosh Lab
The Arnab Ghosh lab studies how cardiopulmonary diseases and inflammatory myopathies may affect hemeprotein maturation.
View Lab
The Neetu Gupta lab studies mechanisms of B cell activation that regulate humoral immunity and B cell-mediated diseases.
Neetu Gupta Lab
The Neetu Gupta lab studies mechanisms of B cell activation that regulate humoral immunity and B cell-mediated diseases.
View Lab
The Thomas Hamilton lab studies how inducible gene expression is controlled during different phases of inflammation.

Thomas Hamilton Lab
The Thomas Hamilton lab studies how inducible gene expression is controlled during different phases of inflammation.
View Lab
The Andrei Ivanov lab studies how actin and myosin influence junction integrity and wound healing in the intestines.

Andrei Ivanov Lab
The Andrei Ivanov lab studies how actin and myosin influence junction integrity and wound healing in the intestines.
View Lab
The Hyun Jung Kim lab explores the biomimetic microphysiological system to uncover fundamental mechanisms of host-microbiome crosstalk in health and disease.

Hyun Jung Kim Lab
The Hyun Jung Kim lab explores the biomimetic microphysiological system to uncover fundamental mechanisms of host-microbiome crosstalk in health and disease.
View Lab
The Feng Lin lab studies complement activation and regulation in diseases like multiple sclerosis and myasenthia gravis.

Feng Lin Lab
The Feng Lin lab studies complement activation and regulation in diseases like multiple sclerosis and myasenthia gravis.
View Lab
The Michelle Longworth lab studies how changes to DNA organization in a cell's nucleus impacts development and disease.

Michelle Longworth Lab
The Michelle Longworth lab studies how changes to DNA organization in a cell's nucleus impacts development and disease.
View Lab
The Kenneth McCurry lab studies the mechanisms that cause complications after lung transplants.

Kenneth McCurry Lab
The Kenneth McCurry lab studies the mechanisms that cause complications after lung transplants.
View Lab
The Christine McDonald lab studies how disruptions in immune response contribue to Crohn's disease.

Christine McDonald Lab
The Christine McDonald lab studies how disruptions in immune response contribue to Crohn's disease.
View Lab
The Jeannette Messer lab investigates the role of gut microbes in chronic inflammatory diseases.

Jeannette Messer Lab
The Jeannette Messer lab investigates the role of gut microbes in chronic inflammatory diseases.
View Lab
The Laura Nagy lab studies how chronic alcohol consumption contributes to liver disease and diabetes.

Laura Nagy Lab
The Laura Nagy lab studies how chronic alcohol consumption contributes to liver disease and diabetes.
View Lab
The Mitchell Olman lab studies the causes of idiopathic pulmonary fibrosis in hopes of developing disease treatments.

Mitchell Olman Lab
The Mitchell Olman lab studies the causes of idiopathic pulmonary fibrosis in hopes of developing disease treatments.
View Lab
The John O'Toole lab studies mitochondrial diseases caused by mutations in the nuclear or mitochondrial genomes.

John O‘Toole Lab
The John O'Toole lab studies mitochondrial diseases caused by mutations in the nuclear or mitochondrial genomes.
View Lab
The Eugene Podrez lab explores how inflammation and oxidative stress contribute to atherosclerosis and thrombosis.

Eugene Podrez Lab
The Eugene Podrez lab explores how inflammation and oxidative stress contribute to atherosclerosis and thrombosis.
View Lab
The Rezaee lab studies the impact of viral infection and environmental factors on airway epithelium and inflammation.

Fariba Rezaee Lab
The Rezaee lab studies the impact of viral infection and environmental factors on airway epithelium and inflammation.
View Lab
The Florian Rieder lab studies mechanisms of intestinal fibrogenesis towards new inflammatory bowel disease treatments.

Florian Rieder Lab
The Florian Rieder lab studies mechanisms of intestinal fibrogenesis towards new inflammatory bowel disease treatments.
View Lab
The Kurt Runge lab studies telomeres and DNA breaks and how they contribute to cell function and disease.

Kurt Runge Lab
The Kurt Runge lab studies telomeres and DNA breaks and how they contribute to cell function and disease.
View Lab
The Sakaguchi lab studies the pathogenesis of liver diseases like biliary atresia and nonalcoholic steatohepatitis.

Takuya Sakaguchi Lab
The Sakaguchi lab studies the pathogenesis of liver diseases like biliary atresia and nonalcoholic steatohepatitis.
View Lab
The Rachel Scheraga lab studies mechanosensitive receptors in the treatment of respiratory distress syndrome.

Rachel Scheraga Lab
The Rachel Scheraga lab studies mechanosensitive receptors in the treatment of respiratory distress syndrome.
View Lab
The Andrea Schlegel lab studies the role of mitochondria in transplantation and other diseases.

Andrea Schlegel Lab
The Andrea Schlegel lab studies the role of mitochondria in transplantation and other diseases.
View Lab
The John Sedor lab studies the molecular and genetic bases of kidney disease to develop new therapies and diagnostics.

John Sedor Lab
The John Sedor lab studies the molecular and genetic bases of kidney disease to develop new therapies and diagnostics.
View Lab
The Thaddeus Stappenbeck lab studies factors that impact inflammation and wound repair and cause inflammatory bowel disease.

Thaddeus Stappenbeck Lab
The Thaddeus Stappenbeck lab studies factors that impact inflammation and wound repair and cause inflammatory bowel disease.
View Lab
The J. Michael Stolley Lab conducts research at the confluence of immunology and oral biology.

J. Michael Stolley Lab
The J. Michael Stolley Lab conducts research at the confluence of immunology and oral biology.
View Lab
The Dennis Stuehr lab studies how nitric oxide biosynthesis impacts cell function and disease.

Dennis Stuehr Lab
The Dennis Stuehr lab studies how nitric oxide biosynthesis impacts cell function and disease.
View Lab
The Adriano Tonelli lab studies the pathobiology of pulmonary arterial hypertension to identify new therapeutic targets.

Adriano Tonelli Lab
The Adriano Tonelli lab studies the pathobiology of pulmonary arterial hypertension to identify new therapeutic targets.
View Lab
The Vidula Vachharajani lab investigates immuno-metabolic response in sepsis and septic shock with specific interest in the role of sirtuin nutrient sensors.

Vidula Vachharajani Lab
The Vidula Vachharajani lab investigates immuno-metabolic response in sepsis and septic shock with specific interest in the role of sirtuin nutrient sensors.
View Lab
The Anna Valujskikh lab studies the immunobiology of memory CD4 T cells in the context of organ transplant.

Anna Valujskikh Lab
The Anna Valujskikh lab studies the immunobiology of memory CD4 T cells in the context of organ transplant.
View Lab
The Yuxin Wang Lab explores cytokine signaling pathways to understand immune responses, particularly in bacterial lung infections and fatty liver disease.

Yuxin Wang Lab
The Yuxin Wang Lab explores cytokine signaling pathways to understand immune responses, particularly in bacterial lung infections and fatty liver disease.
View Lab
The Jijun Xu lab studies new therapies for pain syndromes, including chemotherapy-induced neuropathy and chronic pain.

Jijun Xu Lab
The Jijun Xu lab studies new therapies for pain syndromes, including chemotherapy-induced neuropathy and chronic pain.
View Lab